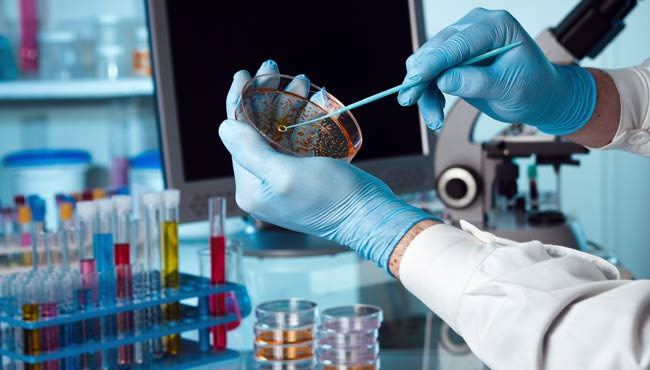

Kasların giderek güçsüzleşmesine ve çoğunlukla 20'li yaşlarda ölüme neden olan kas erimesi hastalığı DMD'nin erken teşhisi için Dokuz Eylül Üniversitesi (DEÜ) Tıp Fakültesi Hastanesi nörolog ve genetik uzmanları işbirliğiyle yapılan çalışmalarda ilerleme sağlandı.
DEÜ Çocuk Genetik Bilim Dalı ve Tıbbi Genetik Anabilim Dalı Başkanı Prof. Dr. Derya Erçal, kas erimesi hastalık grubunda tedavi ile ilgili adımların son yıllarda hızlandığını belirtti.
Kas erimesi hastalık grubundan DMD olarak bilinen "Duchenne Muskuler Distrofi" konusunuda DEÜ'de 1995 yılında moleküler genetik uzmanlar öncülüğünde çalışma başlattıklarını, çalışmalara erken başladıkları için de geniş bir aile ve hasta serisine sahip olduklarını kaydeden Prof. Erçal, "DMD geni bildiğimiz en büyük genlerden biri, 79 ayrı bölümü var. Gendeki kopmalar veya ikizlenmeleri tespit ederek hastaların yüzde 80'ine genetik kesin tanı koyabiliyoruz. Geri kalanına ise bir tek molekülün değişimini bulmak için dizi analizi şansımız olabiliyor, dizi analiziyle de bir tek noktanın değişimini tespit etmek için çalışıyoruz" diye konuştu.
"TEDAVİLER HENÜZ RUTİN HALE GELMEDİ"
Son aylarda yurt dışında yapılan çalışmalarda hem gendeki kopmalarla ilgili hem de tek bir molekülün değişimiyle ilgili umut verici tedavilerin başladığına değinen Erçal, bu tedavilerin henüz rutin haline gelmediğini ve gönüllüler üzerinde yürütüldüğünü bildirdi.
DEÜ'de de moleküler çalışmaların sürdüğünü kaydeden Erçal, şöyle konuştu:
"Bu hastalardaki bozukluğu tespit edip bilgi verdiğimizde nörolog arkadaşlarımız belli grupta olanlara deneysel tedavi önerebiliyor. Bu gruplar genin belirli bölgesinde delesyonu olan ve tek mutasyonu olan hastalar ama yakın gelecekte daha fazla sayıda hastanın geliştirilmeye çalışılan bu tedavilerden yararlanma olanağı bulabileceğine inanıyorum."
ANNE KARNINDA DA TESPİT EDİLEBİLİYOR
Kas erimesi hastalığının bazı belirtileri olduğunu anlatan Prof. Dr. Erçal, bu belirtilerin doğumdan çok kısa süre sonra ortaya çıktığını dile getirdi.
Ailede kas erimesi hastalığı öyküsü varsa, kadın doğum uzmanı önderliğinde anne karnında amniyosentez sıvı alma işlemiyle DMD geninde mutasyon olup olmadığını tespit ettiklerini dile getiren Erçal, "Bu sıvı örneği labortavura geldiğinde kromozom ve gen analizi yöntemiyle inceleyerek DMD geninde bir mutasyon olup olmadığını ya da hangi cins olduğunu belirliyoruz. Eğer varsa ve anne baba hastalıklı bir çocuğa sahip olmak istemiyorsa Etik Kurul kararıyla düşürtülmesi istenebiliyor" ifadelerini kullandı.
25-30'LU YAŞLARDA HAYATINI KAYBEDİYOR
Yeni doğan döneminde de karaciğer testleri sonucu enzimlerdeki yüksekliğin uyarıcı bir belirti olabileceğine dikkati çeken Erçal, "Böyle bir hastalık belirtisi ortaya çıktığında nörologlar genetik testler ister ve hastaya tedavi verir, ne kadar erken tedaviye başlanırsa o kadar iyi sonuç olabilir. Bugün bu hastaları 25-30'lu yaşlarda kaybediyoruz. İleride gen tedavileriyle daha iyi yaşatmak mümkün olabilecektir" şeklinde konuştu.
Anne karnında ya da yeni doğan döneminde fark edilmemesi durumunda DMD hastalığının 3-5 yaşları arasında merdiven çıkma, yürüme sırasında güçsüzlükle ortaya çıkabileceğini anlatan Prof. Dr. Derya Erçal, "Gen analizi yapmak için öncelikle o gen ile ilgili hastalığın hekiminin görüşü gerekiyor" dedi.
Laboratuvarlarda hücreler içinde var olan DNA'lardaki yaklaşık 22 bin genin hepsinde taramaya gitmenin ve tüm hastalıkları tespit etmenin henüz mümkün olmadığına değinen Erçal, şunları kaydetti:
"Belki bir süre sonra bu mümkün olabilecak ama şu an için pratik uygulaması yok. 300, belki bin hastalığın tarandığı yöntem geliştirilmeye başlandı. Maliyetleri oldukça yüksek, diğerlerinin karşılanması pek mümkün olmuyor. Umarım sağlık sistemimiz ileride bu pahalı testleri de uygulama şansı verir."